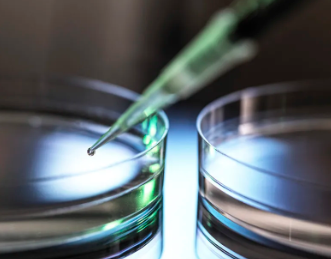
image.png

杭州哪家口服干細(xì)胞醫(yī)院效果顯著?如何選擇最佳治療方案?
2024-10-23 10:04:24 來源: 小編 咨詢醫(yī)生
旨在為大家詳細(xì)解析干細(xì)胞治療的相關(guān)知識(shí),幫助您更好地了解和選擇口服干細(xì)胞治療方案。
一、杭州口服干細(xì)胞醫(yī)院效果顯著的原因
杭州擁有眾多專業(yè)從事干細(xì)胞研究的醫(yī)院,這些醫(yī)院在口服干細(xì)胞治療方面取得了顯著的效果,主要原因是以下幾點(diǎn):
1.高品質(zhì)的干細(xì)胞來源:杭州的干細(xì)胞醫(yī)院采用的干細(xì)胞來源多樣,包括臍帶血、脂肪、骨髓等,這些干細(xì)胞來源豐富,質(zhì)量有保障。
2.先進(jìn)的提取技術(shù):杭州的干細(xì)胞醫(yī)院在干細(xì)胞提取方面采用國際先進(jìn)的技術(shù),確保干細(xì)胞的活性、純度和數(shù)量。
3.專業(yè)的治療團(tuán)隊(duì):杭州的干細(xì)胞醫(yī)院擁有一支專業(yè)的治療團(tuán)隊(duì),包括干細(xì)胞研究專家、臨床醫(yī)生、護(hù)士等,為患者提供全方位的治療服務(wù)。
4.嚴(yán)謹(jǐn)?shù)闹委煼桨福汉贾莸母杉?xì)胞醫(yī)院根據(jù)患者的具體情況制定個(gè)性化的治療方案,確保治療效果。
二、如何選擇最佳治療方案?
選擇最佳治療方案需要考慮以下幾個(gè)方面:
1.了解自身需求:在選擇口服干細(xì)胞治療方案時(shí),首先要明確自己的需求和期望,例如改善身體亞健康、抗衰老、治療某種疾病等。
2.選擇正規(guī)醫(yī)院:選擇具有合法資質(zhì)、口碑良好的干細(xì)胞醫(yī)院進(jìn)行治療??赏ㄟ^網(wǎng)絡(luò)查詢、咨詢專業(yè)人士等方式了解醫(yī)院的口碑和實(shí)力。
3.考慮干細(xì)胞來源:不同來源的干細(xì)胞具有不同的特點(diǎn)和適用范圍。在選擇治療方案時(shí),要了解各種干細(xì)胞來源的優(yōu)缺點(diǎn),選擇最適合自己的方案。
4.評估治療方案:在了解自身需求和醫(yī)院實(shí)力后,與醫(yī)生充分溝通,評估治療方案的可行性和預(yù)期效果。
5.關(guān)注價(jià)格和療程:價(jià)格和療程是選擇治療方案時(shí)需要考慮的因素。要了解不同治療方案的價(jià)格和療程,確保在預(yù)算范圍內(nèi)獲得最佳效果。
6.遵循醫(yī)囑:在治療過程中,要嚴(yán)格遵循醫(yī)生的醫(yī)囑,按時(shí)按量服用藥物,保持良好的生活習(xí)慣。
總之,選擇杭州口服干細(xì)胞醫(yī)院治療時(shí),要全面了解醫(yī)院實(shí)力、干細(xì)胞來源、治療方案等因素,以確保獲得顯著的治療效果。同時(shí),要密切關(guān)注自身身體狀況,遵循醫(yī)囑,積極調(diào)整生活習(xí)慣,以期達(dá)到最佳治療效果。
- 2024-11-21青島有干細(xì)胞注射的醫(yī)院嗎,哪家效果好
- 2024-11-08福建培養(yǎng)干細(xì)胞的醫(yī)院?福建干細(xì)胞療法有哪些優(yōu)勢?
- 2024-11-16干細(xì)胞腎病治療醫(yī)院哪家好,治療效果如何
- 2024-10-20柳州哪家醫(yī)院干細(xì)胞注射技術(shù)最成熟?
- 2024-09-13中國干細(xì)胞十大公司排名,干細(xì)胞什么牌子比較好
- 2024-12-07廣州干細(xì)胞移植機(jī)構(gòu)有哪些企業(yè),權(quán)威榜單為你揭曉
- 2024-08-16國外干細(xì)胞存儲(chǔ)技術(shù)現(xiàn)狀分析
- 2024-10-11干細(xì)胞結(jié)合中藥治療腫瘤靠譜嗎?哪些機(jī)構(gòu)值得信賴?
- 2024-09-23淋巴瘤采干細(xì)胞過程,淋巴瘤做干細(xì)胞移植效果
- 2024-10-07干細(xì)胞儲(chǔ)存合法機(jī)構(gòu)有哪些,如何選擇可靠的存儲(chǔ)服務(wù)
- 2024-08-12干細(xì)胞療法多少錢一個(gè)療程
- 2024-08-29長沙干細(xì)胞抗衰老,詳解費(fèi)用與治療周期
- 2024-09-23捐造血干細(xì)胞有補(bǔ)嘗嗎,捐獻(xiàn)造血干細(xì)胞的補(bǔ)償
- 2024-09-07骨髓瘤干細(xì)胞的過程是怎樣的,移植成功率多少
- 2024-08-14間充質(zhì)干細(xì)胞移植骨關(guān)節(jié)炎能治好嗎
- 2024-09-30干細(xì)胞填充眼袋凹陷效果好不好,與傳統(tǒng)方法有何區(qū)別
- 2024-10-11干細(xì)胞治療鼻炎真的有效嗎?有沒有臨床數(shù)據(jù)支持?
- 2024-09-11植物干細(xì)胞激活技術(shù)原理詳解
